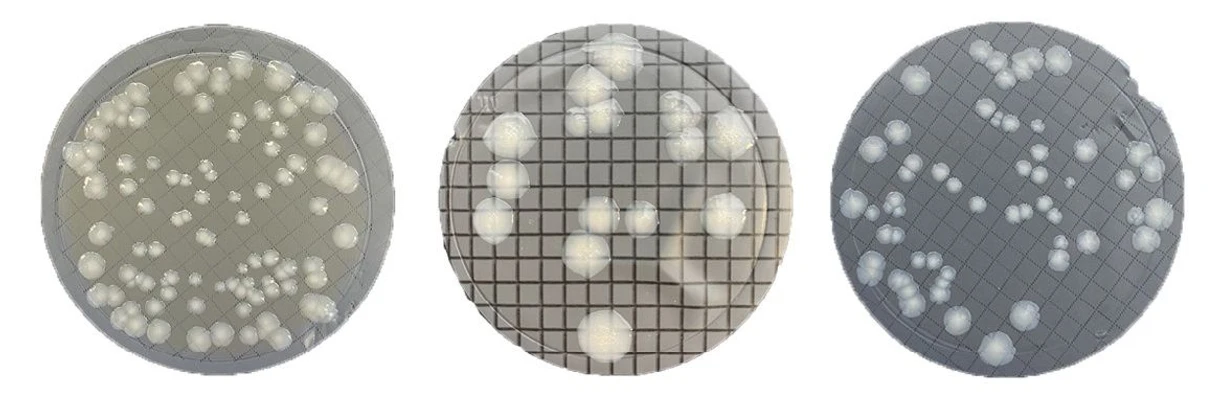
ALS Czech Republic: EnviroMail™11/Europe: Legionella in Waters. Why Testing is Important?!?!: Figure 4: Typical suspected Legionella colonies on agar.

EnviroMail™11/Europe: Legionella in Waters. Why Testing is Important?!?!

ALS Czech Republic: EnviroMail™11/Europe: Legionella in Waters. Why Testing is Important?!?!
Although Legionnaires’ disease is relatively rare, controlling and analyzing Legionella in waters is essential to protect public health, ensure occupational safety, comply with regulations, and prevent the economic and social impacts of Legionnaires’ disease outbreaks. Regular monitoring, maintenance, and appropriate control measures are crucial for a comprehensive Legionella control system.
What is Legionella?
Legionella pneumophila is a naturally occurring waterborne bacteria that can be found at low levels in natural freshwater environments including surface (lakes, streams) and groundwaters. Legionella bacteria may also be present in building water systems like cooling towers and evaporative condensers (within large air conditioning systems), as well as decorative water features, rainwater collection systems, and poorly maintained hot tubs/spas.
Legionella particularly finds the optimal conditions for settlement in areas with heavy sediment accumulation in pipelines. Common „sources“ of this bacterium include areas with stagnant water in systems, such as dead legs in plumbing or air conditioning systems. This bacteria often symbiotically coexists with other microorganisms, such as algae, protozoa, or biofilms in pipelines.
In systems such as these, Legionella can multiply under ideal conditions, which includes warm (25-42°C) stagnant water, and unclean piping and equipment. At temperatures below 20°C, the bacteria is not able to reproduce any more and enters a dormant „sleep“ state. Since Legionella is naturally occurring, the bacteria may never be completely eliminated, but its growth can be controlled. Legionella is capable of rapid proliferation, with a doubling time of just 4 hours. This means that from a single microorganism, up to 64 individuals can emerge within 24 hours, and in a week, this number can reach a staggering 4.4*10¹². For these reasons, it is crucial to monitor and regulate the temperature of water systems and ensure a sufficient flow of water to minimise opportunities for the formation and spread of Legionella.
The most effective measures to control Legionella infection outbreaks include actions to reduce the growth of the bacteria in building water systems and to reduce opportunities for human exposure. Temperature controls, preventing accumulation of stagnant water, adequate disinfection protocols, and regular maintenance and monitoring of water systems typically reduce the occurrence of the bacteria.
 ALS Czech Republic: EnviroMail™11/Europe: Legionella in Waters. Why Testing is Important?!?!: Figure 1: Legionella pneummophila bacteria in lungs, 3D illustration.
ALS Czech Republic: EnviroMail™11/Europe: Legionella in Waters. Why Testing is Important?!?!: Figure 1: Legionella pneummophila bacteria in lungs, 3D illustration.
Why is testing for Legionella important?
Legionella pneumophila is the cause of Legionnaires’ disease, which is a serious and potentially fatal respiratory illness that results in severe pneumonia. The bacteria can also cause a milder illness called Pontiac fever, resulting in flu-like symptoms that typically resolve within a few days without treatment. These illnesses are caused by inhalation of aerosols or water droplets contaminated with the Legionella bacteria; they are not transmitted from person to person.
Routine inspections for Legionella bacteria and appropriate control measures can prevent from Legionnaires’ disease. Regular checks should be done at tourist accommodation sites, hospitals, long-term healthcare facilities, or other settings where sizeable populations at higher risk may be exposed to aerosols containing the bacteria.
Where and when Legionella can be found?
- When: water is maintained between 20-42°C; water contains nutrients; water is stagnant.
- Where: Hot water heaters (calorifiers); atomisers, cooling towers; airconditioning; whirlpools; hydrotherapy baths; showers; domestic water systems; dead legs of pipelines.
 ALS Czech Republic: EnviroMail™11/Europe: Legionella in Waters. Why Testing is Important?!?!: Figure 2: Sources of Legionella spp.
ALS Czech Republic: EnviroMail™11/Europe: Legionella in Waters. Why Testing is Important?!?!: Figure 2: Sources of Legionella spp.
Legislation: EU Regulatory Requirements
With the increasing occurrences of Legionnaires’ disease in recent years, the EU has integrated the regulation of Legionella bacteria into EU Directive 2020/2184. This directive includes the assessment of Legionella concentration among the parameters to be evaluated when determining the quality of drinking water intended for human consumption, and was also extended for monitoring of Legionella bacteria in all drinking water distribution systems, including large domestic water and industrial distribution systems.
The limit for Legionella species was established at 1000 CFU/L.
It’s worth noting that the EU directive requires testing for Legionella spp. and not just Legionella pneumophila.
The Importance of Regular Check-Ups
Regular checks for the presence of Legionella bacteria and appropriate control measures can prevent cases of Legionnaires’ disease at tourist accommodation sites, hospitals, long-term healthcare facilities, or other settings where sizeable populations at higher risk may be exposed to aerosols containing the bacteria.
Recommended measures can include:
- Ensuring regular maintenance, cleaning, and disinfection of water systems, including plumbing systems, cooling towers, hot tubs, and decorative fountains.
- Maintaining cold-water systems below 20°C, and hot-water systems above 50°C to prevent bacterial growth.
- Ensuring proper water flow and circulation in water systems to minimize the risk of stagnant water.
- Disinfecting hot water systems with high levels of (50mg/l) chlorine for 2-4 hours after work on the system and water heaters, and before the beginning of every warm season.
- Regularly cleaning and disinfecting water filters, cooling towers and associated pipes used in air conditioning systems.
Sampling for Legionella tests
When sampling for tests of Legionella in water, it’s important to adhere to certain requirements to ensure accurate and reliable results.
- Sampling Points: Identify and select appropriate sampling points within the water system, specifically targeting areas at a higher risk of Legionella contamination, as discussed above. ALS laboratories provide professional and accredited samples collection.
- Sampling Containers: Use only ALS sterile containers provided for Legionella sampling. These containers are specifically designed to maintain the integrity of the sample and prevent contamination during transportation to the laboratory.
Do not fill them completely, just to the signed level.
 ALS Czech Republic: EnviroMail™11/Europe: Legionella in Waters. Why Testing is Important?!?!: Figure 3: ALS sterile containers for microbiological testing.
ALS Czech Republic: EnviroMail™11/Europe: Legionella in Waters. Why Testing is Important?!?!: Figure 3: ALS sterile containers for microbiological testing.
- Sampling Technique: Follow a proper sampling technique to avoid an unknown contamination. Put on gloves, let the water run for a sufficient period, and fill the sample container to the desired level. Allow hot water to run and sample it at a temperature of 35-50°C.
- Sample Transportation: Once collected, samples should be kept cold (5+/-3°C), but not frozen. Deliver the samples to the laboratory as soon as possible using the provided packaging with ice or ice packs. Samples must be delivered to laboratory or ALS branches within 24 hours from sampling. The holding time (time within which the analysis must commence) for Legionella spp. analysis is 48 hours from sampling.
- Results: Considering the fact that the technological incubation time for samples is 10 days, the reporting for results is approximately 12 days from the delivery of samples to the laboratories.
- Frequency of Sampling: Establish a regular sampling schedule based on the risk assessment of the water system. Regular monitoring is essential, especially in high-risk environments.
ALS Czech Republic: EnviroMail™11/Europe: Legionella in Waters. Why Testing is Important?!?!: Figure 4: Typical suspected Legionella colonies on agar.
ALS Czech Republic: EnviroMail™11/Europe: Legionella in Waters. Why Testing is Important?!?!: Figure 4: Typical suspected Legionella colonies on agar.
Related literature:
- Legionnaires’ disease. Annual Epidemiological Report for 2021.
- Directive (EU) 2020/2184 of the European Parliament and of the Council of 16 December 2020 on the quality of water intended for human consumption
- Legionella water testing and the EU Drinking Water Directive: could potentially harmful Legionella bacteria slip through the gaps? S. Delaney, T. Arcari, O. O’Connor. BioTechniques, 2022.


